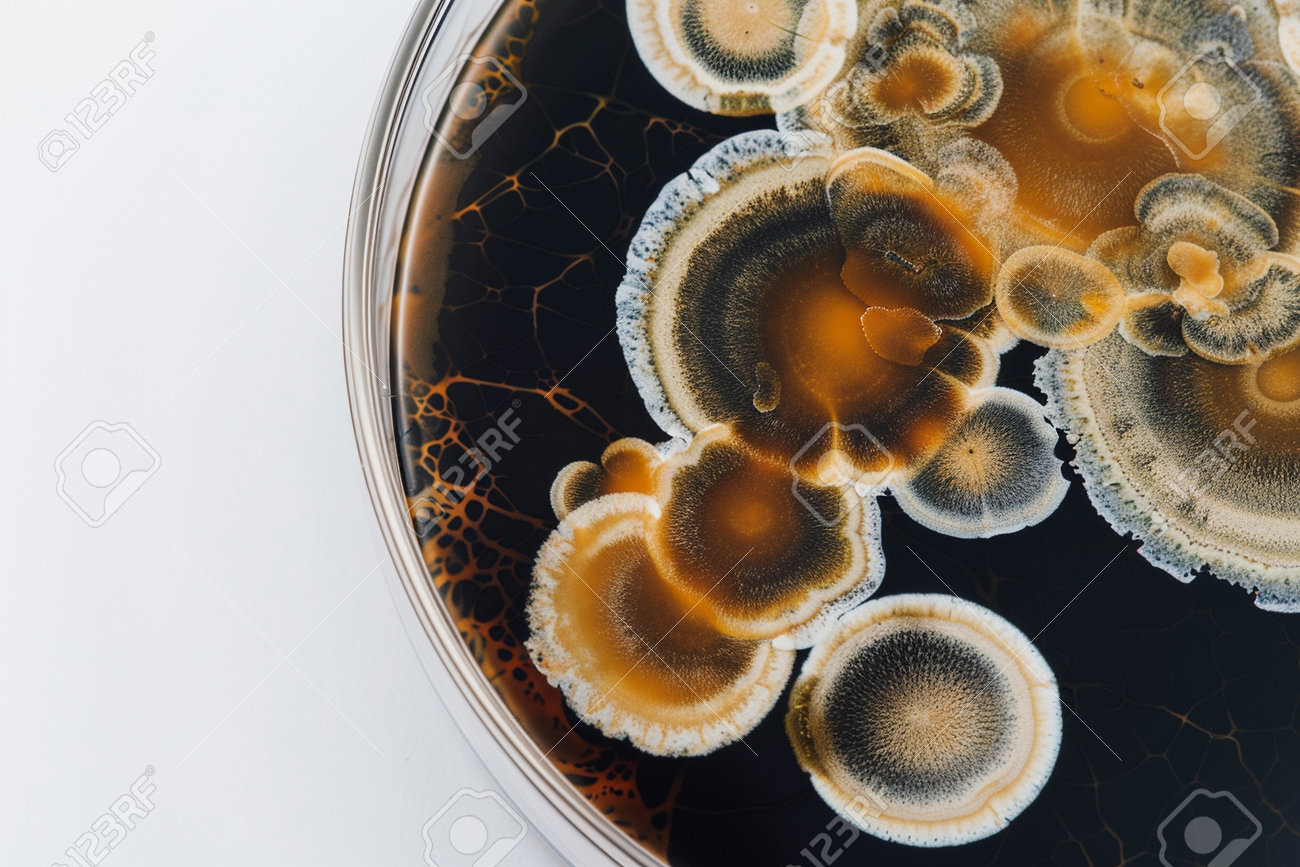
etiam-dictum-ipsum-a-felis

Download
Close
Автор:
id:
Ключевые слова:
abstract, art, bacteria, biology, black, cells, circle, closeup, colony, colors, composition, contrast, culture, dark, detail, discovery, dish, experiment, formation, fungi, growth, intricate, laboratory, macro, microbiology, natural, orange, organic, pattern, petri, research, science, scientific, spores, structure, study, texture, unusual, visual, white,





